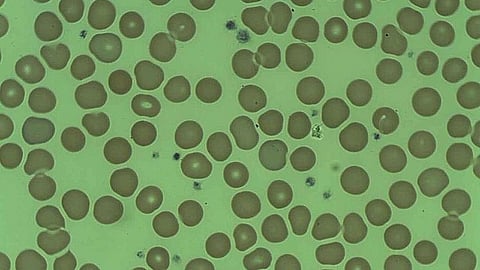

Vitamin B-12 deficiency, known as cobalamine deficiency, is widespread in India with 47% of the population affected and the rest of the population having a borderline level of Vitamin B-12 in the blood. There are several causes for this deficiency. One of the major contributing factors is the large population of Indians consuming a strict vegetarian diet. Therefore, vegetarians and breastfed infants have a major deficiency.
Certain medications can also cause deficiency such as anticonvulsants and proton pump inhibitors as they affect the absorption of the vitamin. In western countries, pernicious anemia is the major cause of Vitamin B 12 deficiency.
An individual requires around 2 to 3 micrograms of Vitamin B 12 daily. Vitamin B 12 is readily available from animal sources such as liver, kidney, fish, eggs, milk, and cheese. The vitamin is synthesized in the human large intestine and stores 2 mg of the vitamin in the liver along with the kidney, heart, and brain which stores another 2mg. These stores are adequate for 2 years. Therefore, this deficiency takes around 2 years to develop after the vitamin stores are completely depleted.
Individuals with vitamin B-12 deficiency may suffer from several disorders like megaloblastic anemia, fatigue, neurological conditions like subacute combined degeneration of the spinal cord, ataxia, peripheral neuropathy (pins and needles sensation), dementia, optic atrophy (visual impairment), impotence, and loss of bladder and bowel control. Some other clinical features include glossitis (beefy red tongue), angular stomatitis (mouth ulcers), purpura, mild jaundice, pigmentation, anorexia, and weight loss. The deficiency can also affect the mental health of individuals by causing mild depression, anxiety, and disorientation.
Vitamin B-12 deficiency can be treated primarily by Vitamin B-12 supplements in vegetarians and people with neuropathic symptoms. Additionally, an improved diet intake is also quite beneficial to overcome the deficiency. A study demonstrates that individuals with diabetes mellitus have higher B-12 levels as they are prescribed B-12 supplements along with oral hypoglycemic drugs. Secondary treatment is the administration of a B-12 injection of 1000mg/day for a week, followed by a second dose of 1000 mg/week for 1 month, a third dose of 1000mg/month for 1 year, and 1000mg/year lifelong. Treatment can be continued until the blood vitamin B12 levels have improved or can be taken lifelong.
Therefore, this deficiency must be taken seriously by individuals and physicians to prevent any disabilities and fatal complications in the future such as neurological deficits, infertility, heart conditions, and pregnancy complications.
References:
NHS (2023). Vitamin B 12 or Folate deficiency anaemia. Available at: https://www.nhs.uk/conditions/vitamin-b12-or-folate-deficiency-anaemia/
Singla, R., Garg, A., Surana, V., Aggarwal, S., Gupta, G., Singla, S. (2019). Vitamin B 12 deficiency is endemic in Indian population: A perspective from North India. Indian Journal of Endocrinology and Metabolism, 23(2), pp.211-214. Doi: 10.4103/ijem.IJEM_122_19.